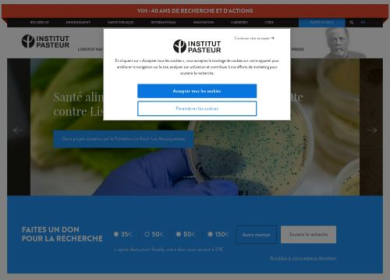

Découvrez Institut Pasteur : recherche scientifique
Le site internet de l'Institut Pasteur, véritable portail informatif sur la Recherche permet aux internautes de tout savoir sur l'histoire de l'Institut, mais aussi de découvrir les recherches menées par les équipes de scientifiques.
Pour sa mission de Santé publique, l'Institut Pasteur porte ses efforts sur la recherche clinique afin de mettre au point des thérapies innovantes.
Pour en savoir plus sur l'Institut Pasteur, ses recherches et son fonctionnement, les internautes sont donc invités à visiter le site Pasteur.fr.


